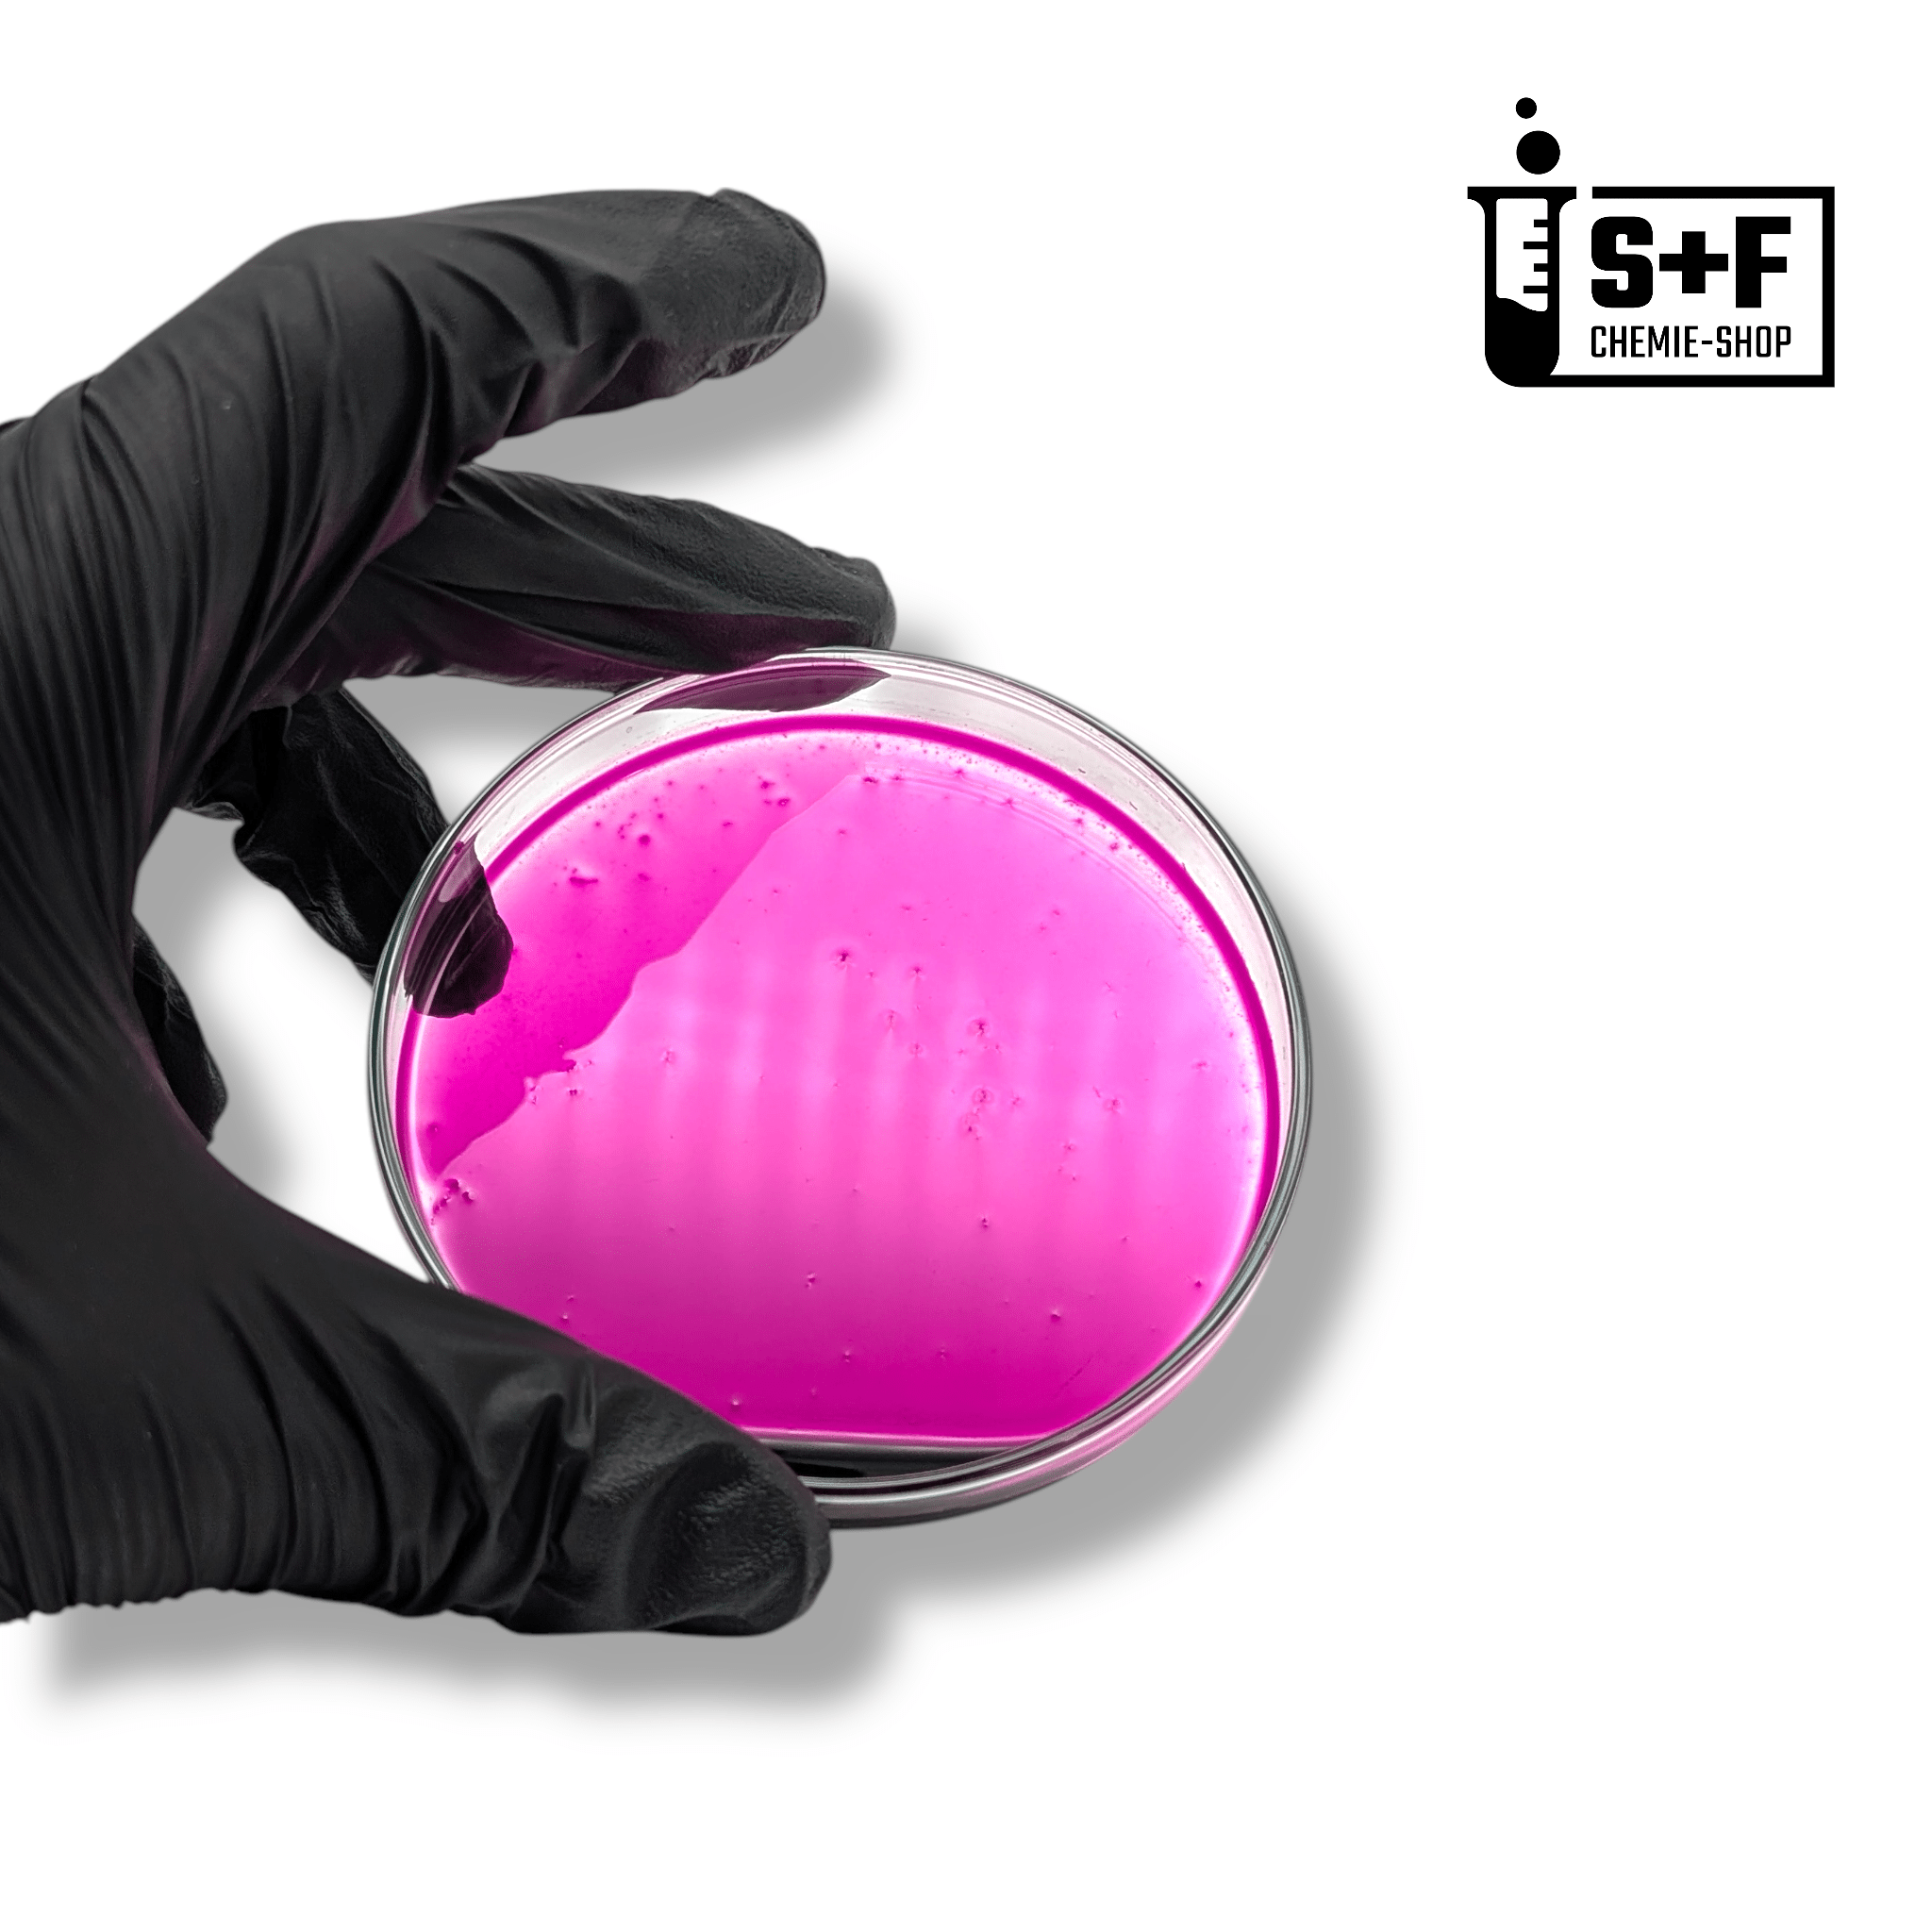

250 ml - Kaliumpermanganat-Lösung (5 %)
1 - 3 Tage Lieferung
Sichere Verpackung
1.000+ Mal verkauft
30 Tage Rückgaberecht
Wir sind bis einschließlich 23.02. im Urlaub. Alle Bestellungen werden direkt am 23.02. versendet!
Informationen zum Stoff:
| Eigenschaft | Beschreibung |
|---|---|
| Stoffbezeichnung | Kaliumpermanganat-Lösung 5 % (wässrig) |
| Alternative Bezeichnungen |
KMnO₄-Lösung, Kalium-Mangan(VII)-oxid-Lösung |
| Summenformel | KMnO₄ (in Wasser gelöst, 5 % w/v) |
| Reinheit | technisch, 5 % ±0,5 % |
| Aggregatzustand | flüssig |
| Farbe | tiefviolett |
| Geruch | geruchlos |
| Molmasse | 158,04 g/mol (Kaliumpermanganat) |
| CAS-Nr. | 7722-64-7 |
| EG-Nr. | 231-760-6 |
| Index-Nr. | 025-022-00-9 |
- ➜ Kein Verkauf an Personen unter 18 Jahre!
- ➜ Nur für Personen mit ausreichenden Kenntnissen empfohlen!
Beispielhafte Anwendungsgebiete für Kaliumpermanganat-Lösung:
- Desinfektionsmittel
- Aquaristik / Aquarium
- Wasseraufbereitung / Wasserbehandlung
- Oxidationsmittel in der Chemie (z.B. für Nachweise, Titration etc.)
- Geruchsneutralisation / Reinigung organischer Verunreinigungen
- Färbe- und Beizmittel
Kennzeichnung gemäß Verordnung (EG) Nr. 1272/2008 (CLP)
Signalwort: Gefahr
GHS-Piktogramme:

P260: Staub/ Rauch/ Gas/ Nebel/ Dampf/ Aerosol nicht einatmen.
P310: Sofort GIFTINFORMATIONSZENTRUM oder Arzt anrufen.
Hinweise vom S+F Chemie-Shop Team:
1) Die 5 %ige Kaliumpermanganat-Lösung ist ein starkes Oxidationsmittel. Bei längerer Lagerung kann es zu Ausfällungen oder Kristallbildung kommen. Dies beeinträchtigt die Wirksamkeit nicht – durch vorsichtiges Erwärmen im Wasserbad oder kräftiges Schütteln lässt sich die Lösung wieder homogenisieren..
2) Bitte beachten Sie die Gefahren- und Sicherheitshinweise auf der Verpackung.
3) Von Kindern Fernhalten!
Umfüllen in andere Behältnisse:
Achten Sie darauf, dass das Behältnis für die Lagerung des jeweiligen Stoffs geeignet ist und keine Verwechslungsgefahr mit Lebensmittelverpackungen besteht. Schneiden Sie unser Produktetikett aus und bringen Sie es fest an das neue Behältnis an, um dieses gemäß CLP-Verordnung* korrekt zu kennzeichnen.Hintergrundinformationen zum Stoff:
Kaliumpermanganat-Lösung (Summenformel: KMnO₄, 5 % w/v) ist eine tiefviolette, stark oxidierende Flüssigkeit. Es handelt sich um eine wässrige Lösung des Kaliumsalzes der Permangansäure und gehört zur Stoffgruppe der Permanganate. Kaliumpermanganat ist sehr gut wasserlöslich und wirkt stark oxidierend, desinfizierend und geruchsneutralisierend.
Die Lösung findet Anwendung in der Chemie (z. B. als Oxidationsmittel und in der Analytik), in der Wasseraufbereitung (zur Entfernung von Eisen, Mangan und Geruchsstoffen), in der Teich- und Aquariumspflege (gegen Parasiten und Algen, stark verdünnt) sowie in der Reinigung und Desinfektion von Oberflächen und Geräten. In der Medizin wurde sie früher in stark verdünnter Form zur Haut- und Wunddesinfektion verwendet.
Über uns:
Wir beschäftigen an jedem Standort mindestens eine Person, die die Sachkunde nach §11 der Chemikalien-Verbotsverordnung (ChemVerbotsV) besitzt.Kontakt:
📩 E-Mail: kontakt@sf-chemie-shop.dePairs well with

250 ml - Kaliumpermanganat-Lösung (5 %)
Anna, Markus und 857 weitere Kunden nutzen unsere Produkte
If you have any questions, you are always welcome to contact us. We'll get back to you as soon as possible, within 24 hours on weekdays.
-
Shipping Information
Use this text to answer questions in as much detail as possible for your customers.
-
Customer Support
Use this text to answer questions in as much detail as possible for your customers.
-
FAQ’s
Use this text to answer questions in as much detail as possible for your customers.
-
Contact Us
Use this text to answer questions in as much detail as possible for your customers.
Product details
Collapsible row 1
Use this text to share information about your brand with your customers. Describe a product, share announcements, or welcome customers to your store.
Collapsible row 2
Use this text to share information about your brand with your customers. Describe a product, share announcements, or welcome customers to your store.
Collapsible row 3
Use this text to share information about your brand with your customers. Describe a product, share announcements, or welcome customers to your store.
Collapsible row 4
Use this text to share information about your brand with your customers. Describe a product, share announcements, or welcome customers to your store.
Image with text
Share information about your brand with your customers. Describe a product, share announcements, or welcome customers to your store.
Share information about your brand with your customers. Describe a product, share announcements, or welcome customers to your store.
S+F Chemie-Shop
Image with text
Share information about your brand with your customers. Describe a product, share announcements, or welcome customers to your store.
S+F Chemie-Shop in Zahlen:
Verkaufte Produkte 📦
🏆 Zufriedene Kunden
FAQ:
📦 Wie lange dauert die Lieferung meiner Bestellung?
"Die Lieferzeiten können je nach Ihrem Standort und der Art der bestellten Chemikalien variieren. In der Regel beträgt die Lieferzeit 1-3 Werktage. ⏱️ Sobald Ihre Bestellung versandt wurde, erhalten Sie eine Versandbestätigung mit einer Sendungsverfolgungsnummer per E-Mail. Weitere Informationen zu unseren Versandbedingungen finden Sie hier. 🚚"
📍Woher kommen die Produkte und wo werden Sie abgefüllt?
"Unsere Chemikalien beziehen wir ausschließlich von zertifizierten Partnern aus der EU.🇪🇺 Abgepackt und versendet werden die Chemikalien mit viel ❤️ in Deutschland.🇩🇪"
↩️ Kann ich einen gekauften Artikel umtauschen und wenn ja, wie lange?
"Ja! Ungeöffnete Produkte können bei uns problemlos innerhalb von 30 Tagen nach Erhalt, ohne Angabe von Gründen zurückgegeben werden, sofern sie sich im Originalzustand befinden und die Verpackung unbeschädigt ist. Bitte kontaktieren Sie unseren Kundenservice 💬 um die Rücksendung zu arrangieren und eine Anleitung für die nötigen Schritte zu erhalten. Bitte beachten Sie, dass geöffnete Chemikalien aus Sicherheitsgründen und aufgrund gesetzlicher Bestimmungen nicht zurückgegeben werden können."
⭐️ Wie kann ich sicherstellen, dass die von mir gekauften Produkte von hoher Qualität sind?
"Wir beziehen unsere Chemikalien ausschließlich von zertifizierten und vertrauenswürdigen Herstellern aus der EU. 🇪🇺 Alle Produkte durchlaufen strenge Qualitätskontrollen, bevor sie in unser Lager aufgenommen werden. Zusätzlich bieten wir detaillierte Produktspezifikationen und zahlreiche Informationen für unsere Chemikalien an, um Ihnen maximale Transparenz und Sicherheit zu gewährleisten. ✅"
💳 Welche Zahlungsmethoden kann ich verwenden?
"Wir akzeptieren eine Vielzahl von Zahlungsmethoden, um Ihnen den Einkauf so bequem wie möglich zu machen. Dazu gehören Kreditkarten, PayPal, Banküberweisungen/ Kauf auf Rechnung (über Klarna), sowie Apple Pay, Google Pay und Shop Pay. Alle Transaktionen sind durch modernste Sicherheitsmaßnahmen geschützt, damit Ihre Daten jederzeit sicher sind. 🔒"
🔐 Sind meine Daten im S+F Chemie-Shop sicher?
"Ja, Ihre Sicherheit hat für uns oberste Priorität. Wir verwenden moderne Verschlüsselungstechnologien und halten uns an die höchsten Sicherheitsstandards, um Ihre persönlichen und Zahlungsinformationen zu schützen. Ihre Daten werden nur für den Zweck Ihrer Bestellung verwendet und nicht an Dritte weitergegeben. ✅"

